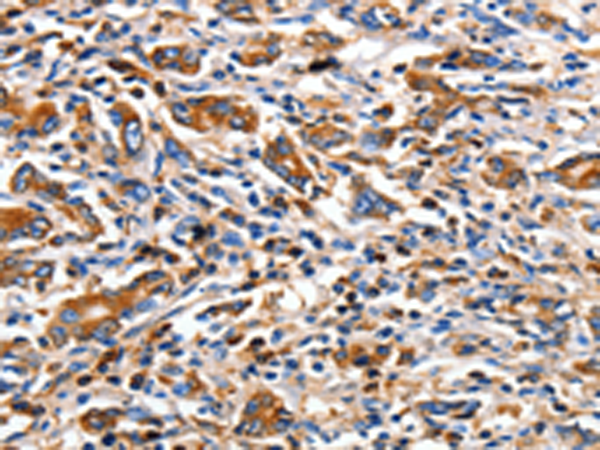

-
分类: 科研抗体货号: P10762别名: MDL1; MDL-1; CLECSF5应用: IHC反应种属: Human
-
分类: 科研抗体货号: P10761别名: KACL; PILAR; UNQ5792应用: IHC反应种属: Human
-
分类: 科研抗体货号: P10778别名: SGS; SKV应用: WB,IHC反应种属: Human, Mouse
-
分类: 科研抗体货号: P10760别名: CKLFH; CKLFH1; CKLFSF1应用: IHC反应种属: Human
-
分类: 科研抗体货号: P10765别名: AWAL, BEC1, TMVCF, CPETRL1应用: IHC反应种属: Human, Mouse, Rat
-
分类: 科研抗体货号: P10777别名: CRF应用: IHC反应种属: Human, Mouse, Rat
-
分类: 科研抗体货号: P10759别名: BIE, EHK, K10, KPP, BCIE, CK10应用: IHC反应种属: Human, Mouse, Rat
-
分类: 科研抗体货号: P10764别名: CB1; CNR; CB-R; CB1A; CB1R; CANN6; CB1K5应用: IHC反应种属: Human, Mouse, Rat
-
分类: 科研抗体货号: P10775别名: DRP3; ULIP; CRMP4; DRP-3; LCRMP; CRMP-4; ULIP-1应用: WB,IHC反应种属: Human, Mouse, Rat
-
分类: 科研抗体货号: P10758别名: K16; CK16; K1CP; NEPPK; FNEPPK; KRT16A应用: WB,IHC反应种属: Human, Mouse, Rat

鄂公网安备42018502007531号
鄂公网安备42018502007531号

